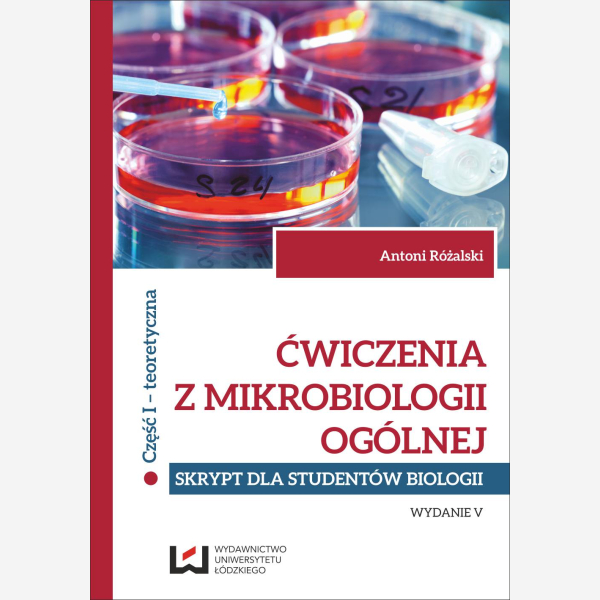
Ćwiczenia z mikrobiologii ogólnej. Wydanie V

- Archeologia
- Bibliologia i informatologia
- Bibliotekoznawstwo
- Biologia
- Chemia
- Ekonomia i zarządzanie
- Etnologia i antropologia kulturowa
- Filologia polska
- Filologie obce
- Filozofia
- Fizyka
- Geografia
- Historia
- Informatyka
- Językoznawstwo
- Judaica
- Kultura i sztuka
- Kulturoznawstwo
- Matematyka
- Pedagogika
- Podręczniki dla cudzoziemców
- Politologia i stosunki międzynarodowe
- Prawo
- Psychologia
- Socjologia
- Varia
- 100 Lat Niepodległości
- Akademia Samorządowa
- Akademia Zarządzania i Finansów
- Aktywni (nie)pełnosprawni
- Analecta Literackie i Językowe
- Bibliotheca Litteraria
- Bibliotheca Philosophica
- Biografia i Badanie Biografii
- Byzantina Lodziensia
- Filmo!znawcy
- Gerontologia
- Interdyscyplinarne Studia Miejskie
- Interpretacje Literackie
- Jerzy Giedroyc i Świadkowie Historii
- Judaica Łódzkie
- Jurysprudencja
- Literaturoznawstwo. Sylwetki
- Manufactura Hispánica Lodziense
- Nauka Sztuki – Sztuka Nauki
- Oblicza feminizmu
- Oblicza Wojny
- Perspektywy Biograficzne
- Polska Kultura Filmowa
- Research on Science & Natural Philosophy
- Series Ceranea
- Skuteczne Zdziwienie
- Sztuka-Media-Kultura
- Twórczość i Edukacja
- Łódzkie Studia z Językoznawstwa Angielskiego i Ogólnego
Ćwiczenia z mikrobiologii ogólnej. Wydanie V
Skrypt dla studentów biologii. Cz. I teoretyczna. Cz. II praktyczna
Stan magazynowy:
Autor: Antoni Różalski
Liczba stron: 260
Rok wydania: 2014
ISBN: 978-83-7171-635-5
e-ISBN: 978-83-7969-214-9
Język publikacji: PL
Format e-book: pdf
- Opis produktu
- Spis treści
- Recenzje produktu (0)
Mikrobiologia jest nauką o drobnoustrojach (mikroorganizmach). Zajmuje się cechami morfologicznymi, właściwościami biochemicznymi, rolą w środowisku naturalnym, właściwościami chorobotwórczymi, jak również zastosowaniem drobnoustrojów w przemyśle. Podstawowy schemat badania drobnoustrojów obejmuje: wstępną obserwację makroskopową i mikroskopową, wyosobnienie interesującego nas ustroju w postaci czystej hodowli, określenie jego cech morfologicznych, typu wzrostu na podłożach stałych i płynnych, zbadanie jego właściwości biochemicznych i fizjologicznych oraz ustalenie ewentualnej roli wyizolowanego mikroorganizmu w środowisku naturalnym, w przebiegu choroby lub możliwości wykorzystania w procesie przemysłowym. Zwalczanie drobnoustrojów jest także jedną z dziedzin mikrobiologii ogólnej we wszystkich przypadkach, w których obecność niektórych z nich jest wręcz szkodliwa. Istnieje też możliwość zakażenia mikrobiologicznego, dlatego pracownicy laboratoriów mają najwyższe kwalifikacje zawodowe i duże doświadczenie, wykonują swoją pracę posługując się wyłącznie sprzętem zmechanizowanym i korzystają z pełnego zabezpieczenia osobistego.
Książka zawiera przegląd zagadnień mikrobiologii ogólnej, łączących się tematycznie z problematyką ćwiczeń odbywanych przez studentów specjalności: mikrobiologicznej, biochemicznej i biofizycznej, fizjologicznej oraz biologii środowiskowej.
W związku z niepełnym opracowaniem niektórych tematów, podana została literatura pomocnicza i uzupełniająca.
Nikt jeszcze nie napisał recenzji do tego produktu. Bądź pierwszy i napisz recenzję.
Tylko zarejestrowani klienci mogą pisać recenzje do produktów. Jeżeli posiadasz konto w naszym sklepie zaloguj się na nie, jeżeli nie załóż bezpłatne konto i napisz recenzję.